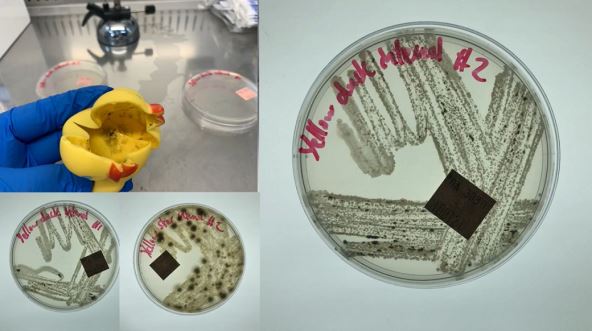
decje igracke gumene igracke pune bakterija

Gotovo da nema deteta koje nema barem jednu gumenu igračku koju voli da "vodi" sa sobom na kupanje. Ove igračke su jako praktične jer su uglavnom iz jednog dela, pa roditelji ne brinu da li deca mogu da progutaju deo, da nešto otkinu...
Međutim, kada ovo vidite, neće vam biti baš svejedno da se vaš mališan igra gumenim igračkama.
Mikrobiolog dr Kameron Džouns na Facebooku je pokazao kako izgleda unutrašnjost ovih igračaka. On je gumenu patku presekao na pola, a zatim pokazao da se unutra nalazi buđ!
Dr Džouns je upozorio da gljivice, bakterije i buđ koji se nalaze unutra mogu da doved do infekcija očiju, ušiju i kože, alergijskih reakcija, povraćanja, dijareje...
Njegova poruka usledila je nakon što je jedna mama prethodno pokazala kako izgleda unutrašnjost gumenih igračaka njenog deteta i zgrozila sve – unutrašnjost je bukvalno crna od buđi.
Mikrobiolog je objasnio da se u unutrašnjosti gumenih igračaka, zbog vode koja se unutra zadržava, stvara supstanca koja se naziva biofilm. Zapravo je reč o različitim mikroorganizmima, uključujući bakterija, buđ i gljivice, koje se lepe jedni za druge i formiraju sluzavu supstancu.
"Istraživanja su pokazala da 70 odsto gumenih igračaka sadrži crnu, sluzavu supstancu, koja potencijalno može da bude veoma opasna", saopštio je dr Džouns.
Da biste sprečili da u igračku uđe voda i nakupe se bakterije, mikrobiolog savetuje da sve rupe na gumenim igračkama popunite silikonom.
"I pored toga, uvek ih osušite nakon upotrebe, otkuvajte ih i dezinfikujte, kako biste bili sigurni da su čiste i bezbedne za decu".
(MONDO)
Budite bolje informisani od drugih, PREUZMITE MONDO MOBILNU APLIKACIJU.


